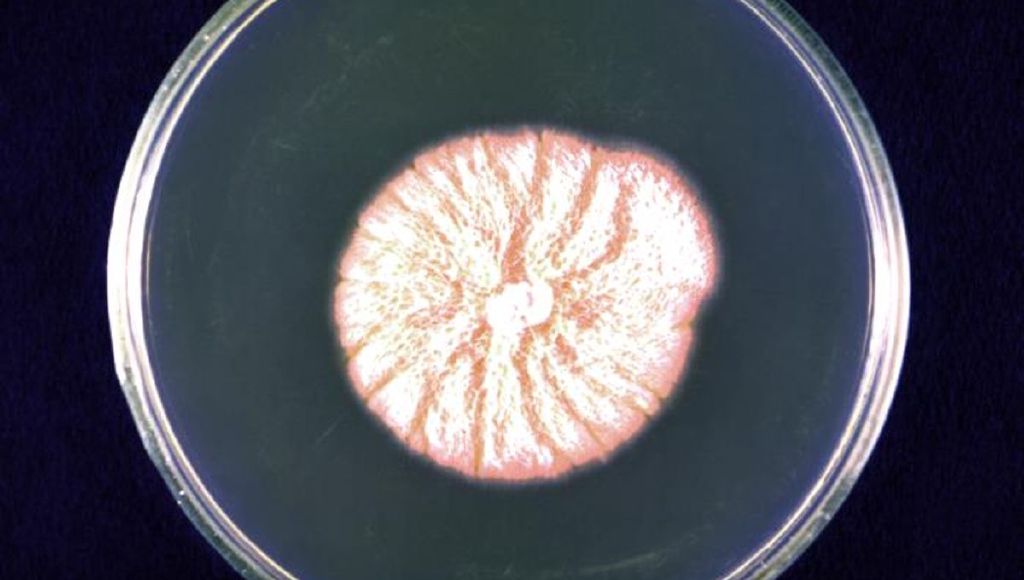

IFLScience
shared a link post in group #IFLScience

www.iflscience.com
Rare Fungal Infection Sickens Dozens Of Workers At Paper Mill In US
Blastomycosis is caught by inhaling the spores of the fungus.

IFLScience

shared a link post in group #IFLScience
www.iflscience.com
Rare Fungal Infection Sickens Dozens Of Workers At Paper Mill In US
Blastomycosis is caught by inhaling the spores of the fungus.
Comment here to discuss with all recipients or tap a user's profile image to discuss privately.
<div data-postid="rxnpvon" [...] </div>